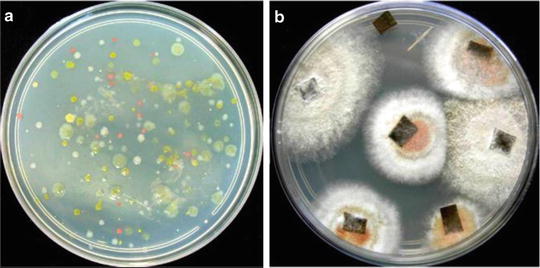
Biological Control of Insect-Pest and Diseases by Endophytes | SpringerLink

If you are looking for IJMS | Free Full-Text | The Role of Plant–Microbe Interactions and you've visit to the right page. We have 8 Images about IJMS | Free Full-Text | The Role of Plant–Microbe Interactions and like Biological Control of Insect-Pest and Diseases by Endophytes | SpringerLink, Isolation and characterization of an extracellular antifungal protein… and also Potential of siderophore-producing bacteria for improving heavy metal. Read more:
IJMS | Free Full-Text | The Role Of Plant–Microbe Interactions And
 www.mdpi.com
www.mdpi.com plant phytoremediation pollutants microbe air interactions ijms exploitation role
Deciphering Bacterial Mechanisms Of Root Colonization - Knights
 sfamjournals.onlinelibrary.wiley.com
sfamjournals.onlinelibrary.wiley.com colonization root bacterial fig wiley bacteria mechanisms deciphering environmental interactions
IJMS | Free Full-Text | Plant Growth Promoting And Biocontrol Activity
 www.mdpi.com
www.mdpi.com plant growth endophytes promoting biocontrol streptomyces activity interactions microbe rhizosphere representation ijms microorganisms figure spp mdpi favouring possible g001
Potential Of Siderophore-producing Bacteria For Improving Heavy Metal
metal plant bacteria siderophore rhizosphere heavy plants microbe siderophores metals phytoremediation phytoextraction interaction growth producing bacterial figure toxicity microbes uptake
Our 11 Favorite Bacteria Art Submissions From ASM's Petri-Dish Picasso
 invisiverse.wonderhowto.com
invisiverse.wonderhowto.com petri dish bacteria asm contest picasso submissions favorite wonderhowto
Isolation And Characterization Of An Extracellular Antifungal Protein…
 www.slideshare.net
www.slideshare.net endophytic fungal isolation endophytes antifungal extracellular microbes
Biological Control Of Insect-Pest And Diseases By Endophytes | SpringerLink
link.springer.com
link.springer.com insect pest endophytes biological diseases control fig
Vai Trò Và Tầm Quan Trọng Của Vi Sinh Vật Nội Sinh đối Với Cây Trồng
Colonization root bacterial fig wiley bacteria mechanisms deciphering environmental interactions. Insect pest endophytes biological diseases control fig. Plant growth endophytes promoting biocontrol streptomyces activity interactions microbe rhizosphere representation ijms microorganisms figure spp mdpi favouring possible g001